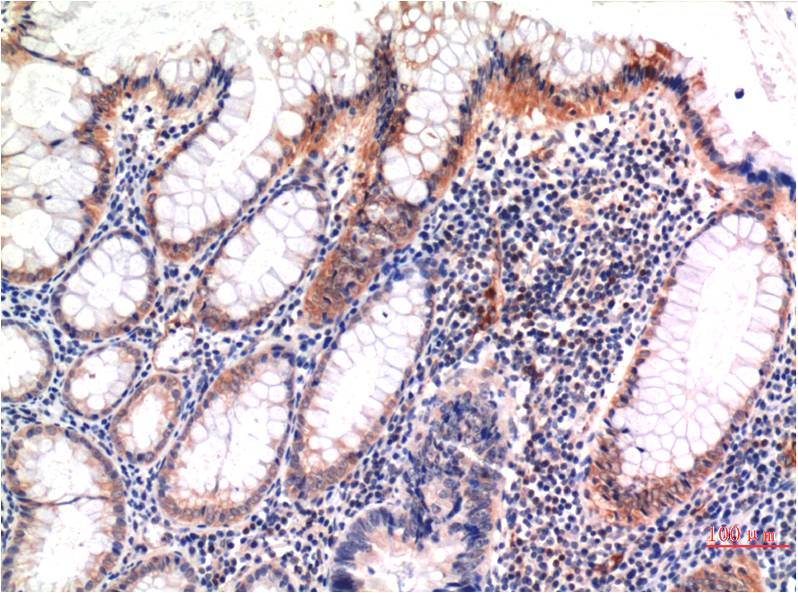

1
/
of
2
MLKL (Phospho Ser358) Monoclonal Antibody (6F8)
MLKL (Phospho Ser358) Monoclonal Antibody (6F8)
MLKL (Phospho Ser358) Mouse Monoclonal Antibody (6F8). Isotype: IgG1. Species Reactivity: Human. Source: Mouse. Antigen: Synthetic Peptide. Composition and storage: 1 mg/mL in PBS, pH 7.4, containing 0.02% sodium azide and 50% glycerol. Store at -20C. Stable for one year from the date of shipment.
Catalog No:
RA10156
Regular price
$311.00 USD
Regular price
$239.00 USD
Sale price
$311.00 USD
Unit price
/
per
Couldn't load pickup availability
Product Details
Application(s)
IHC
Species Reactivity
Human
Source
Mouse
Ab Type
Monoclonal
Isotype
IgG1
Dilution
IHC 1:100-200
Storage Condition and Shelf Life
1 mg/mL in PBS, pH 7.4, containing 0.02% sodium azide and 50% glycerol. Store at -20C. Stable for one year from the date of shipment.
Analyte
MLKL
Regulatory Status
For Research Use Only